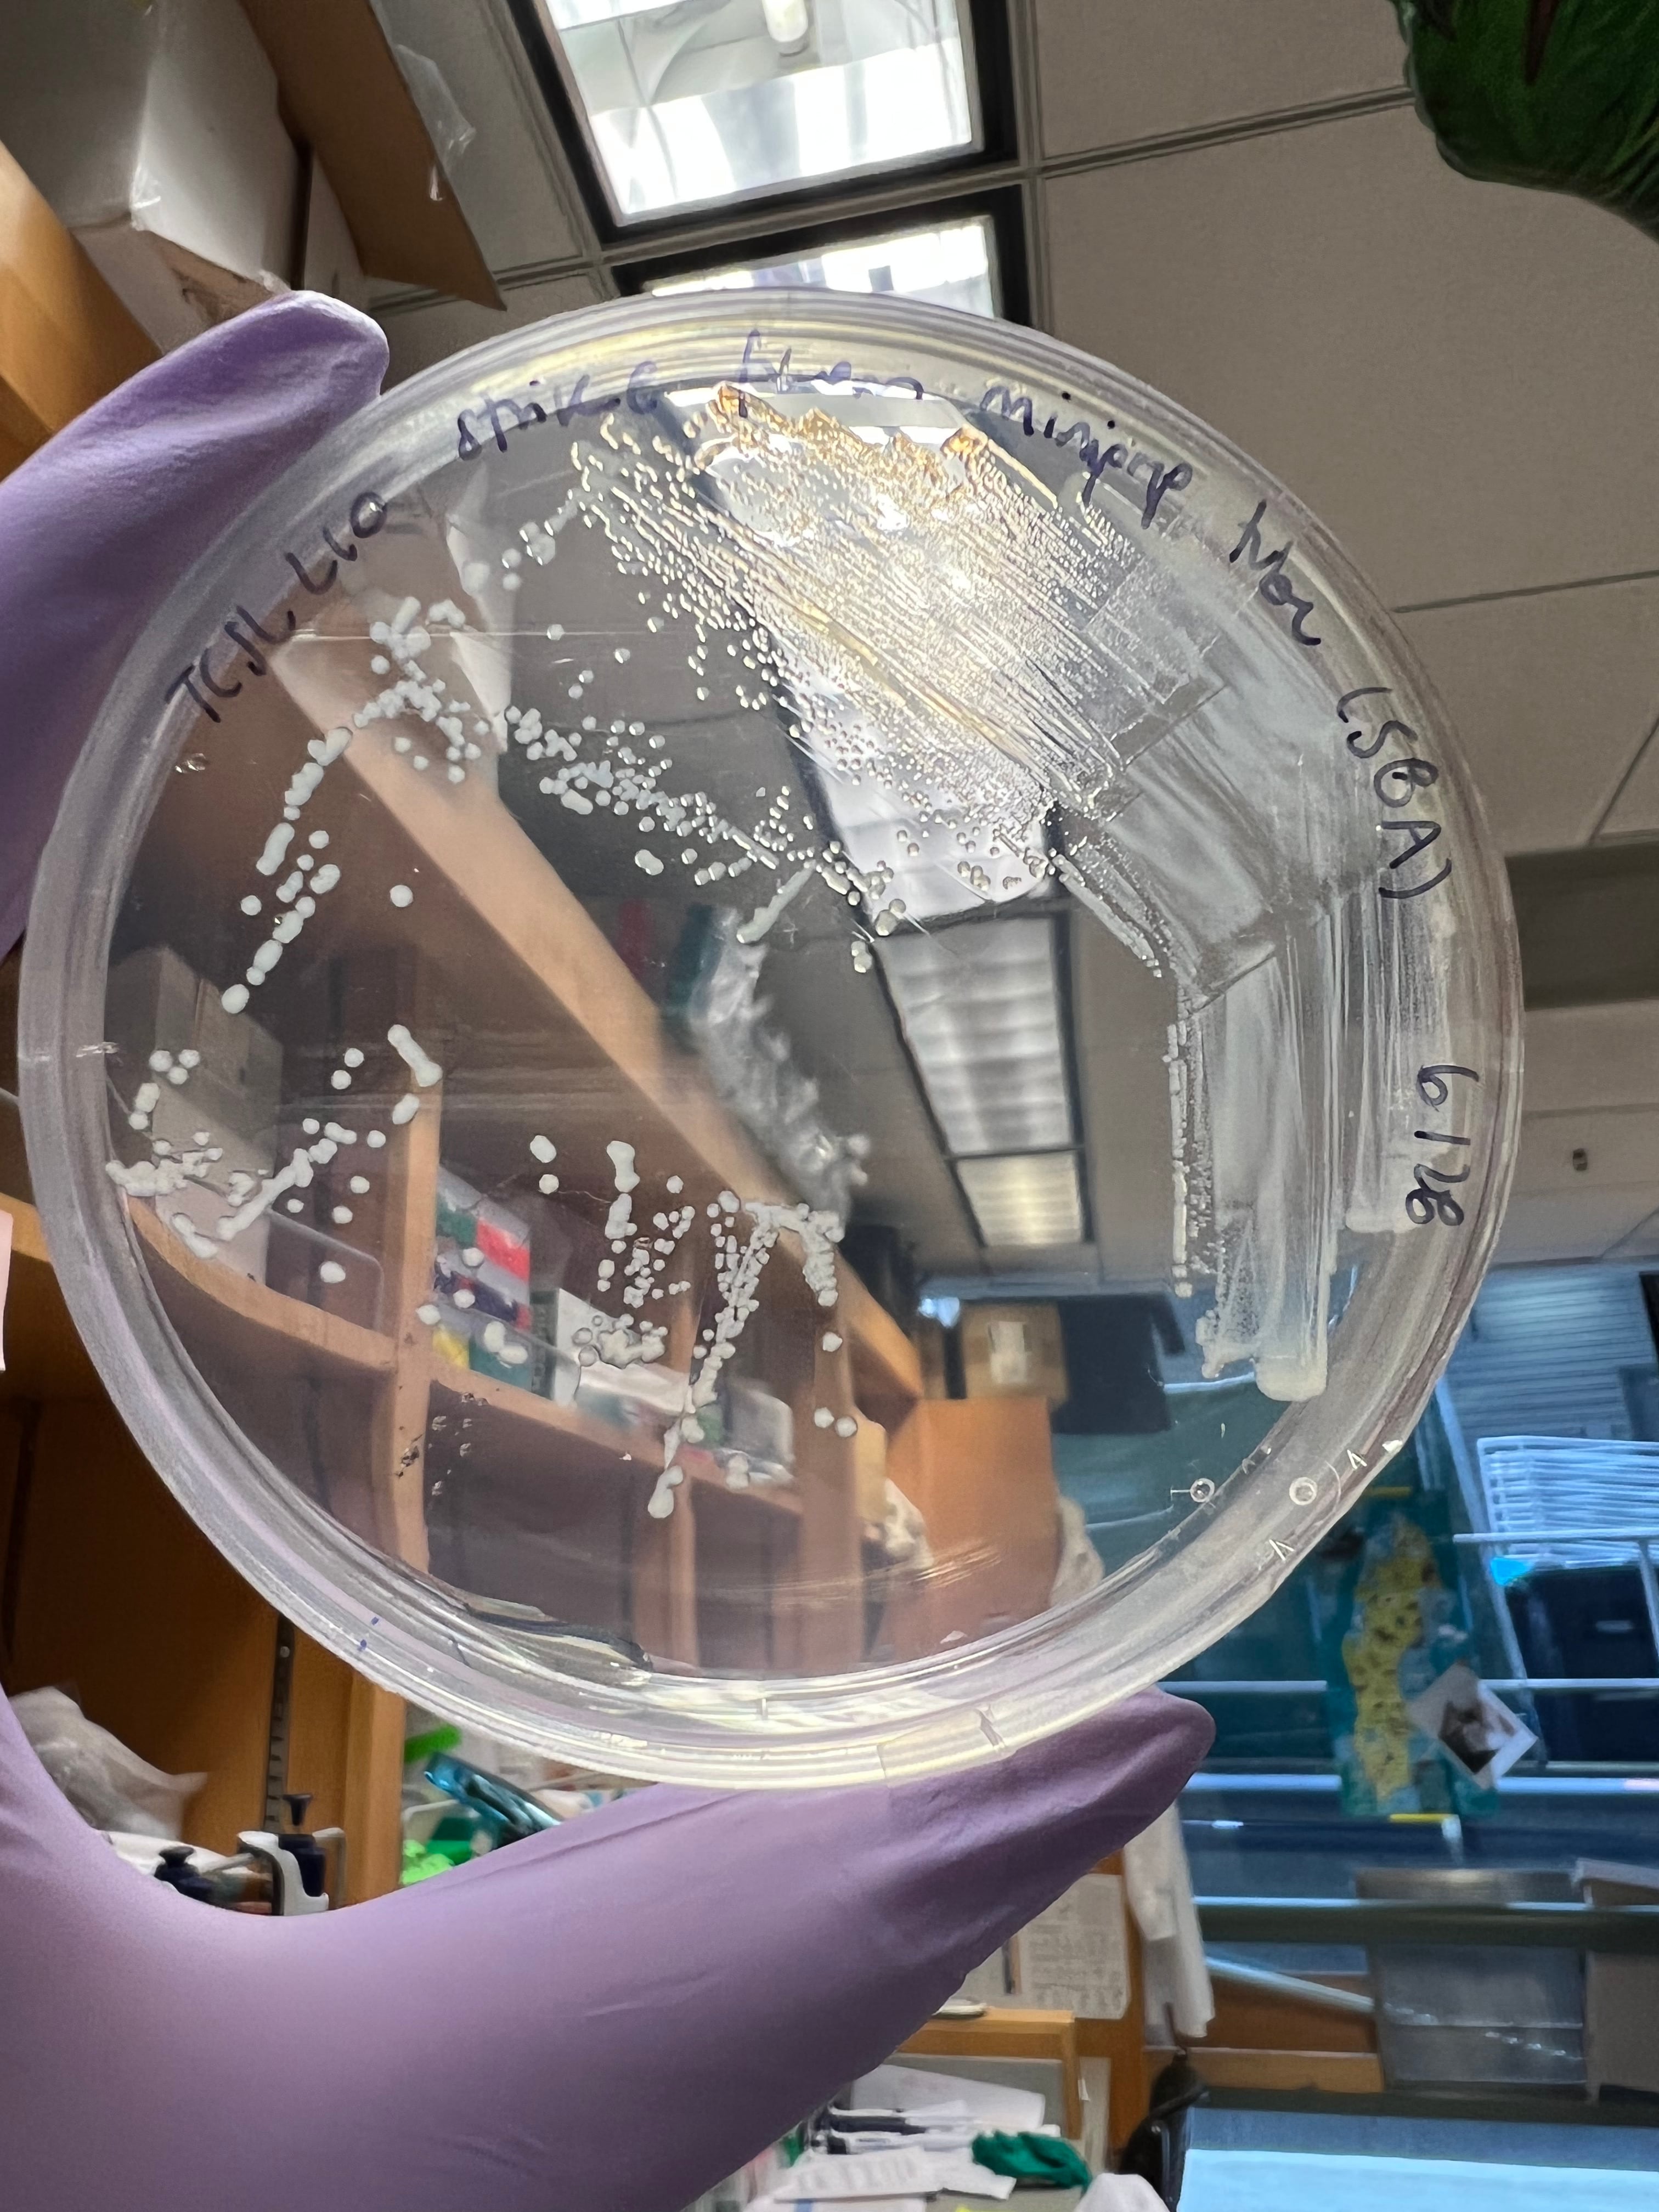
En el MIT, María José Durán trabaja en reprogramación celular, reescribiendo el código de ADN de las células. En la imagen, detalle del trabajo en el laboratorio

Las mejores ideas para curar enfermedades no siempre vienen del que más sabe, sino del que pregunta diferente. Suena imposible, pero no lo es. El único obstáculo es que nosotros, los científicos, fallamos en traducir lo que hacemos. Pareciera que nos encantara la complejidad, los términos técnicos, las publicaciones incomprensibles.
Hoy quiero cambiar eso. Le voy a explicar cómo funciona la biología sintética, de manera que no solo la entienda, sino que pueda imaginar la próxima cura usted mismo.
Empecemos describiendo nuestro canvas, las células humanas. Para entender qué es una célula, hagamos un zoom desde lo más grande hasta lo microscópico. Primero, está el cuerpo humano. Dentro, los sistemas que lo componen, como el sistema inmunitario, el respiratorio, el cardiovascular... Estos sistemas están compuestos de órganos: corazón, pulmones, riñones. Y los órganos, a su vez, se dividen en tejidos, que son grupos de células que trabajan juntas en una tarea específica. Por ejemplo, un grupo de células se contraen para bombear sangre, otro grupo transmite mensajes eléctricos para coordinar los latidos, etcétera. Cada una de estas células tiene un “libro” con la información necesaria para cumplir su función.
Describamos ahora nuestro problema: las enfermedades. De una manera muy general, podemos considerar las enfermedades como una falla en el contenido o la lectura de la información que contiene cada célula. Al fallar, las células reciben instrucciones incorrectas: “multiplíquense sin control” (cáncer), “ataquen tejido sano” (enfermedades autoinmunes), “no produzcan esta proteína vital” (diabetes). Y una vez que las células siguen estas instrucciones equivocadas, la enfermedad ya está en marcha.
Durante décadas, nuestra solución ha sido usar fármacos que administran “lo que no se produjo” o bloquean “lo que no se debió producir”. Pero estos fármacos son herramientas externas: afectan todo el cuerpo y el paciente depende de ellos de por vida. Hoy, la biología sintética propone una nueva avenida: ¿Y si entramos al código y reescribimos las instrucciones desde adentro? Podemos restaurar funciones perdidas o incluso darles a las células capacidades que nunca tuvieron.
La biología sintética se convierte, entonces, en nuestra herramienta. Funciona porque las células son, fundamentalmente, máquinas lectoras. Y, como toda máquina, siguen el manual que les demos.
Si le proporcionamos nueva información, la célula la leerá y ejecutará. Para ello, preparamos la información en “el idioma que la célula lee”, que son cuatro letras –A, T, G, C (adenina, timina, guanina y citosina)–, las cuales conforman el ADN. Por ejemplo, la secuencia “ATGGCATCC...” podría significar “produce esta proteína”. De ahí, encapsulamos la información molecular y, de maneras bioquímicas, logramos que esas moléculas lleguen a la célula para que sean leídas y ejecutadas.
En este enlace puede ver una ilustración del interior de una célula, representada como una máquina procesadora de información.
Mi vida cambió cuando me enteré de que unas de las células que podemos “editar” son las células inmunes. ¡Claro! Estas son las células que se especializan en detectar enfermedades y defender al cuerpo, y al fallar, surgen problemas como cáncer o enfermedades autoinmunes.
Específicamente en el cáncer, las células pierden la capacidad de reconocer las células malignas y de destruirlas. En las enfermedades autoinmunes, estas fallan en distinguir lo propio de lo extraño, y empiezan a atacar tejidos sanos. Sin embargo, si podemos reescribir sus instrucciones, podemos enseñarles qué buscar y cómo atacar, de modo que convertimos el problema en solución.
Esto ya es realidad. Las terapias CAR-T, aprobadas desde el año 2017, toman células inmunes del propio paciente y les instalan “antenas” para reconocer características más específicas del cáncer de ese paciente. Luego las reinyectan.
Esas células reprogramadas se convierten en cazadores, patrullan la sangre y los tejidos, y destruyen de una manera más efectiva y específica todas aquellas células que poseen “la firma de cáncer”. Ciertas leucemias y linfomas que hace diez años eran terminales, ahora tienen pacientes en remisión completa.
Acá, la ilustración de una célula inmune (izquierda) atacando una célula cancerígena (derecha).
Entonces, la pregunta ya no es si esto es posible, sino qué haremos con este conocimiento.
¿Qué instrucciones le daría usted a una célula? ¿Será posible convencer a las células cancerígenas de que detengan su crecimiento descontrolado? ¿Habrá manera de especificarle a una célula inmune que no ataque un órgano trasplantado, aunque no sea propio? ¿Podremos ordenarles a células del corazón que reparen tejidos dañados después de un infarto?
Detrás de cada una de estas preguntas, hay una enfermedad que podríamos curar y todo empieza cuando alguien se atreve a preguntar: “¿y si pudiéramos?“.
María José Durán es la primera costarricense que cursa un doctorado en Bioingeniería en el MIT.